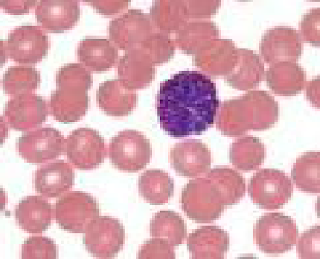

Identifique nas lâminas as estruturas, os tipos celulares e o tipo de tecido.
Figura 1
a) lamelas, fibroblastos, lacuna, eritrócitos, plaquetas e tecido estriado esquelético.
b) lamelas ósseas, canal de harvers, lacuna, canalículos, sistema de harvers e tecido ósseo.
figura 2
a) endósteo e tecido ósseo
b) fibroblastos e tecido conjuntivo.
Dica:
Ø
Canal de Harvers : localizado no centro do
sistema de Harvers: revestido por endósteo e contém nervos e vasos.
Ø
Endósteo : é formado por fibras
reticulares e osteoblastos.
Ø
Periósteo: sua camada mais superficial contém de colágenos
e fibroblastos.
Ø
Fibras de Sharpey: são feixes de fibras de colágeno
do periósteo que penetram o tecido ósseo e prendem firmemente o periósteo ao
osso.
Ø Fibroblastos: São as células mais comuns
no tecido conjuntivo Propriamente dito. São alongados, com núcleo grande, claro
e com nucléolo




.png)

.png)









Nenhum comentário:
Postar um comentário